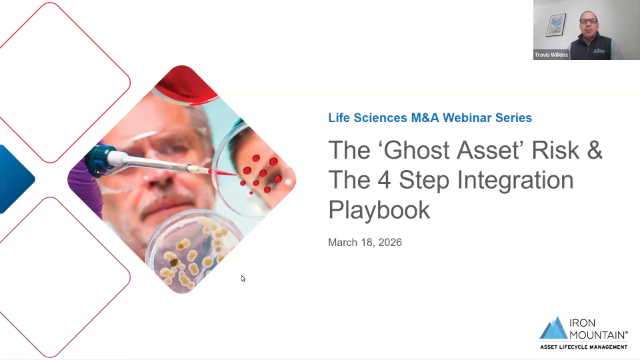

Webinars, videos and virtual events
Stay current with the latest webinars on Data Management. To continue your learning, browse more than 100,000 webinars, videos and virtual events covering hundreds of focused tech and business topics available on TechTarget's BrightTALK.com platform.
Featured Data Management Webinars
-
Scaling AI Agents: Breaking the Inference Memory Wall Across Compute, Storage and Networking
Enterprise AI at scale requires meeting the demands of high performance inference. In this webinar, we examine how Supermicro's accelerated computing...more
Play March 25 2026| 51 mins More on: Data Center, Data Center Infrastructure, compute -
Driving AI Investment Success with GenAI: Practical Strategies for 2026
AI initiatives often face resistance—not because they lack potential, but because they’re seen as risky, expensive and hard to justify. Leaders are ...more
Play February 25 2026| 35 mins More on: AI, Artificial Intelligence, ROI
-
BSIMM16 Insights: Trends Shaping Software Security
AI is reshaping software security faster than ever. The BSIMM16 report, built on insights from 111 firms, shows what’s working—and what’s next. Since...more
Remind Me April 09 2026| 41 mins More on: Application Security, Cyber Security, Software Development -
Bring Snowflake To Your Data: Powering Analytics And AI On The Lakehouse
You have data sitting in a lakehouse—Parquet files, Delta Lake or Apache Iceberg—but turning that data into fast, reliable production-grade analytics...more
Play March 27 2026| 30 mins More on: AI, Snowflake, delta lake -
AI That Answers with Authority: Trusted AI in 30 Minutes
AI is everywhere. However, AI you can trust in production is rare. In real enterprises, especially regulated, data-rich environments, teams hit the ...more
Play March 27 2026| 33 mins More on: Data Platform, AI, Artificial Intelligence -
Accelerating Mergers & Acquisitions: A Digital Approach to Seamless Data Migration
Mergers and acquisitions are often hindered by the challenge of unifying disparate systems and data, leading to operational inefficiencies and ...more
Play March 27 2026| 40 mins More on: Mergers and Acquisitions, Digital Transformation, Artificial Intelligence -
The ‘Ghost Asset’ Risk & The 4 Step Integration Playbook
Mergers and acquisitions create opportunity – but also IT complexity. From overlapping infrastructures to data security risks, the technology ...more
Play March 27 2026| 35 mins More on: Mergers and Acquisitions, Asset Lifecycle Management, Information Management -
Beyond the Talent Gap: Strategies to Build and Retain Your Future Data Center Team
The data center industry is facing a critical staffing crisis, yet traditional recruitment and retention efforts are falling short. Join us this ...more
Play March 25 2026| 59 mins More on: Data Center Management, Data Center Infrastructure, Data Center Efficiency -
Identidad Bajo Control: Estrategias de Acceso y Gobierno
¡Descubre el poder de la Identidad! Únete al webinar de SailPoint LATAM y aprende cómo proteger tu organización en el mundo digital actual y ...more
Play March 26 2026| 65 mins More on: Identity Management, Data access, Access Management -
Getting Data Fit: From Data Debt to AI-Ready with Pentaho Data Optimizer
Is your organization racing toward AI adoption while drowning in data chaos? You're not alone. Join Stephen Catanzano, Senior Analyst at Omdia, and ...more
Play March 26 2026| 19 mins More on: AI, Artificial Intelligence, Data Management -
Applying AI in AP: Balancing Automation and Oversight
AI has quickly become a foundational component of accounts payable processes, making the question within finance teams no longer whether to use AI, ...more
Play March 27 2026| 57 mins More on: AI, AI Finance, Finance Automation